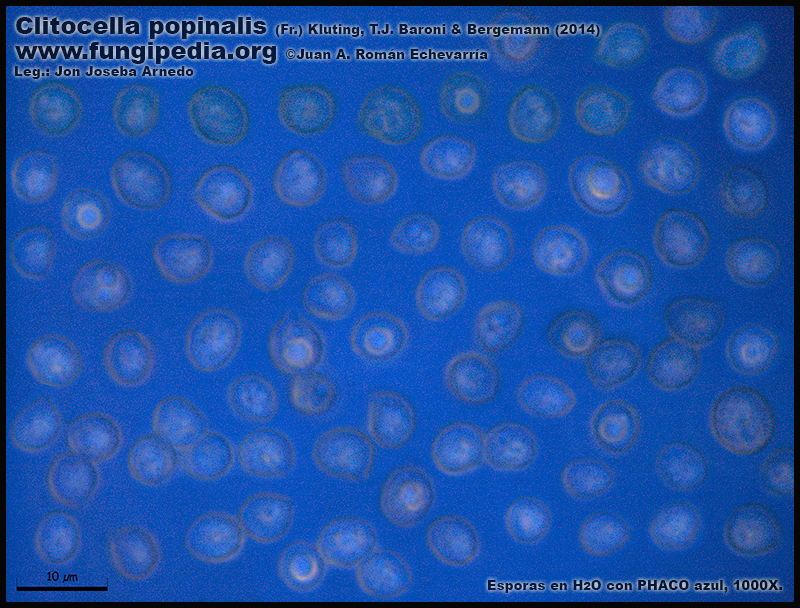

- Foro
- Foros sobre Micología de fungipedia
- Microscopía
- Clitocella popinalis (Fr.) Kluting, T.J. Baroni & Bergemann (2014). Microscopy
 Clitocella popinalis (Fr.) Kluting, T.J. Baroni & Bergemann (2014). Microscopy
Clitocella popinalis (Fr.) Kluting, T.J. Baroni & Bergemann (2014). Microscopy
- Juan Andrés Román
-
 Autor del tema
Autor del tema
- Fuera de línea
- Spammer
-

Menos
Más
- Mensajes: 2558
- Gracias recibidas: 2756
7 años 8 meses antes #99559
por Juan Andrés Román
Por favor, Identificarse para unirse a la conversación.
- txelu
-

- Fuera de línea
- Moderador
-

Menos
Más
- Mensajes: 802
- Gracias recibidas: 621
7 años 8 meses antes #99562
por txelu
Respuesta de txelu sobre el tema Clitocella popinalis (Fr.) Kluting, T.J. Baroni & Bergemann (2014). Microscopy
Aupa Juan , parece que hay poca informacion en la red sobre el hayazgo enhora buena y un saludo.
El siguiente usuario dijo gracias: Juan Andrés Román
Por favor, Identificarse para unirse a la conversación.
- Josep Torres
-

- Fuera de línea
- Moderador
-

Menos
Más
- Mensajes: 8745
- Gracias recibidas: 8379
7 años 8 meses antes #99563
por Josep Torres
Respuesta de Josep Torres sobre el tema Clitocella popinalis (Fr.) Kluting, T.J. Baroni & Bergemann (2014). Microscopy
Gracias Juan Andrés, a esta la conocía por Rhodocybe popinalis, me costará acostumbrarme a las nuevas denominaciones, a partir del 2014 Clitocella popinalis, un género con apenas 3 o 4 especies.
Enhorabuena a tí y a Joseba por el hallazgo, al parecer una especie poco frecuente.
Un fuerte abrazo, campeón
Enhorabuena a tí y a Joseba por el hallazgo, al parecer una especie poco frecuente.
Un fuerte abrazo, campeón
El siguiente usuario dijo gracias: Juan Andrés Román
Por favor, Identificarse para unirse a la conversación.
- javier
-

- Fuera de línea
- Moderador
-

Menos
Más
- Mensajes: 5617
- Gracias recibidas: 4356
7 años 8 meses antes #99565
por javier
Respuesta de javier sobre el tema Clitocella popinalis (Fr.) Kluting, T.J. Baroni & Bergemann (2014). Microscopy
Anda miarma, vaya post con todo lujo de detalles 
Un abrazo figura
Un abrazo figura
El siguiente usuario dijo gracias: Juan Andrés Román
Por favor, Identificarse para unirse a la conversación.
- Héctor
-

- Fuera de línea
- Moderador
-

Menos
Más
- Mensajes: 1022
- Gracias recibidas: 1026
7 años 8 meses antes #99577
por Héctor
Respuesta de Héctor sobre el tema Clitocella popinalis (Fr.) Kluting, T.J. Baroni & Bergemann (2014). Microscopy
Menuda micro más completa, es un lujazo
El siguiente usuario dijo gracias: Juan Andrés Román
Por favor, Identificarse para unirse a la conversación.
- Juan Andrés Román
-
 Autor del tema
Autor del tema
- Fuera de línea
- Spammer
-

Menos
Más
- Mensajes: 2558
- Gracias recibidas: 2756
7 años 8 meses antes #99582
por Juan Andrés Román
Respuesta de Juan Andrés Román sobre el tema Clitocella popinalis (Fr.) Kluting, T.J. Baroni & Bergemann (2014). Microscopy
El siguiente usuario dijo gracias: Josep Torres
Por favor, Identificarse para unirse a la conversación.
- Foro
- Foros sobre Micología de fungipedia
- Microscopía
- Clitocella popinalis (Fr.) Kluting, T.J. Baroni & Bergemann (2014). Microscopy
Tiempo de carga de la página: 0.058 segundos

Foro de micología